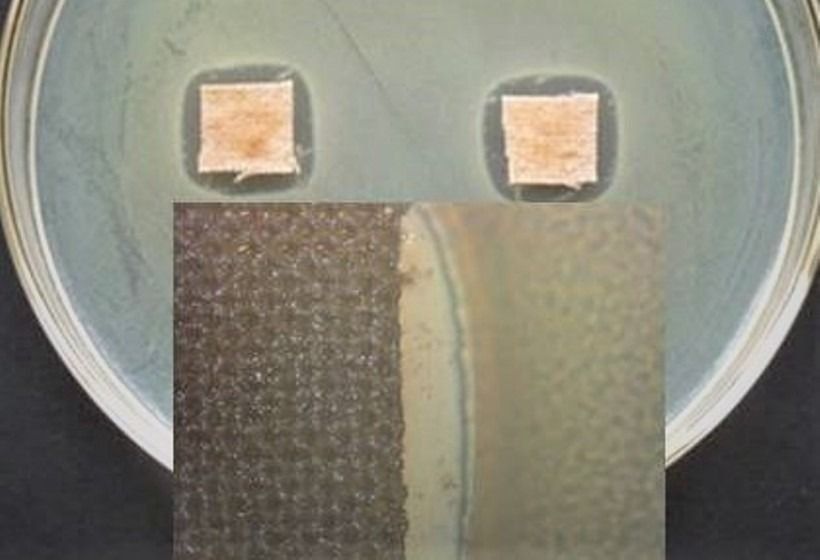

La ciencia argentina se puso al frente para aportar soluciones frente a la propagación del coronavirus en todo el territorio nacional. Hasta el momentos se presentaron 710 Ideas Proyecto (IP) que en pocos días se presentaron a la convocatoria lanzada a finales de marzo por la Agencia Nacional de Promoción de la Investigación, el Desarrollo Tecnológico y la Innovación (Agencia I+D+i) para financiar iniciativas vinculadas al diagnóstico, control, prevención, tratamiento y monitoreo del COVID-19. Al igual que muchos expertos del país, los científicos platenses enviaron dos interesantes propuestas para combatir al virus.
En ese marco, los investigadores del Centro de Investigación y Desarrollo en Ciencias Aplicadas “Dr. Jorge J. Ronco” (CINDECA, CONICET-UNLP-CICPBA), presentaron un proyecto que prevé la formulación de un producto a partir de un compuesto químico inorgánico que podría inhibir al COVID-19 en la indumentaria y elementos de seguridad utilizados por agentes sanitarios. Se trata del óxido de zinv (ZnO), un polvo blanco presente en el mineral zincita y que, producido sintéticamente, es posible modificar sus propiedades fisicoquímicas para darle distintas aplicaciones.
En colaboración con el Centro de Investigación y Desarrollo en Tecnología de Pinturas (CIDEPINT, CONICET-UNLP-CICPBA), expertos del CINDECA ya habían observado la capacidad que, bajo ciertas condiciones de preparación, tiene el óxido de zinc para evitar el crecimiento de hongos. Más tarde volvieron a comprobar el efecto pero en relación a bacterias. Con estos antecedentes, los expertos indagaron en la bibliografía para saber si existían estudios realizados en virus, y encontraron que efectivamente unos años antes se había logrado verificar la capacidad para reducir la acción de H1N1 y H5N1, cepas responsables de otras gripes.
“Ya hemos probado la acción que tiene el ZnO para eliminar o inhibir el crecimiento de distintos microorganismos, entonces la idea de nuestro proyecto es prepararlo con determinadas propiedades para alcanzar ese resultado e incorporarlo a una pintura o aerosol que sirvan para impregnar las telas de barbijos y guardapolvos, como así también las máscaras protectoras con pantallas de plástico”, explica Jorge Sambeth, investigador del CONICET en el CINDECA y responsable de la IP.

Esta propuesta también involucra a otras instituciones y espacios del CONICET La Plata, como el Instituto de Física La Plata (IFLP, CONICET-UNLP) y la Planta Piloto Multipropósito (PLAPIMU-LASEISIC, CICPBA) en la fabricación de los materiales, y al Instituto de Biotecnología y Biología Molecular (IBBM, CONICET-UNLP) y la Facultad de Veterinaria de la UNLP para realizar los ensayos con virus similares al responsable del COVID-19.
La segunda idea, en tanto, es impulsada por el IFLP y consiste en el armado de una cerrada de luz ultravioleta (UV) para la desinfección de elementos de uso cotidiano que pueden ir desde llaves y billeteras hasta las bolsas de la verdulería o paquetes de comida entregado por delivery. Aunque la tecnología es muy conocida y utilizada en el mundo entero a distintas escalas –se emplea tanto para la limpieza de pequeños insumos de laboratorio como para la de ascensores y colectivos, tal el uso que se le da en China, por ejemplo– la novedad de este proyecto es que se piensa como un equipo doméstico o para comercios de barrio que ven perjudicadas sus ventas durante la cuarentena.

“Pensamos en la posibilidad de desinfectar objetos en una cámara parecida a un microondas pero un poco más grande, con seis lámparas y superficies reflectantes. Tendría bandejas extraíbles a distintas alturas para poder colocar varias cosas pequeñas, o sacarlas e introducir, por ejemplo, un casco de moto o el calzado al volver al hogar. De esta manera, nos aseguramos de que no estamos llevando el virus a nuestras casas”, explicó el responsable del proyecto, Guillermo Arturo Muñoz Medina.

La radiación a la que se refiere es la que se conoce como UV de onda corta, dueña de excelentes propiedades desinfectantes que no dejan residuos ni dañan los alimentos. “Por el momento, apuntamos a armar un prototipo sencillo y económico, con materiales que están disponibles y se consiguen fácilmente. Si resulta exitoso, se puede construir algo más elaborado y a mayor escala, y pensamos que realmente tendría un impacto enorme en la sociedad”, señaló. Y agregó: “Las mayores expectativas están puestas en la búsqueda de una vacuna y es lógico porque eso terminaría con la enfermedad, pero mientras tanto también hay que pensar en solucionar las complicaciones paralelas que se generan. Por eso quisimos acudir a una tecnología bien consolidada para atender el problema que afecta la economía de los pequeños comercios y hogares”.